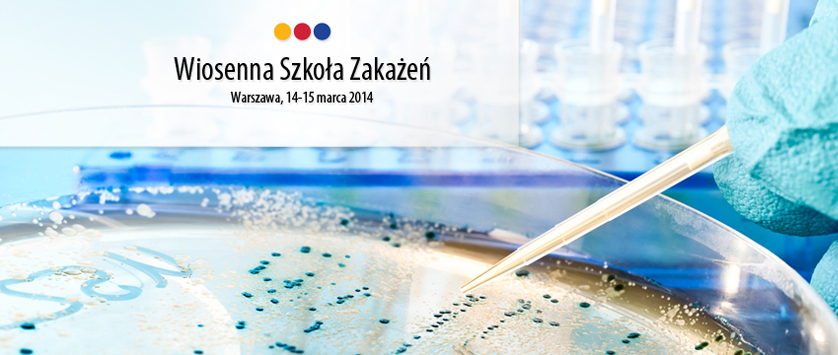
Wiosenna Szkoła Zakażeń - Sesja hematologiczna już dostępna

Leczenie wspomagające

8.12.2014
prof. Iwona Hus
Onkologia w przyszłości – nadzieje na skuteczniejsze leczenie, ale……

12.11.2014
dr n. med. Marta Morawska
Kserostomia- obraz kliniczny, patogeneza i leczenie

2.09.2014
dr n. med. Marta Morawska
Akupunktura w PN wywołanej bortezomibem i talidomidem

1.09.2014
Hematoonkologia.pl
Rozszerzenie refundacji dla Noxafilu- nowe wskazania refundacyjne od 1 września 2014

2.07.2014
Hematoonkologia.pl
Będziemy więcej dopłacać do leków wspomagających chemioterapię

30.06.2014
prof. J. Kowalczyk
Zakażenia grzybicze – od profilaktyki do leczenia

4.06.2014
dr n. med. Marta Morawska
Kombinacja piperacyliny/tazobaktamu z tigecykliną u pacjentów hematologicznych wysokiego ryzyka z gorączką neutropeniczną

22.05.2014
Rynek Zdrowia
Granica między lekami chemicznymi i biologicznymi jest coraz bardziej płynna

7.05.2014
MSD Polska Sp. z o.o.
Informacja o refundacji produktu leczniczego Noxafil

6.05.2014
Hematoonkologia.pl
Zaproszenie na sesję firmową Sandoz, 19 Kongres EHA, Mediolan

5.05.2014
dr n. med. Marta Morawska
Diagnostyka inwazyjnych zakażeń grzybiczych – rekomendacje ECIL
18.04.2014
prof. Walentyna Balwierz
Wiosenna Szkoła Zakażeń - Sesja hematologiczna już dostępna

18.03.2014
dr n. med. Marta Morawska
Diagnostyka inwazyjnych zakażeń grzybiczych -rekomendacje grupy ECIL

17.03.2014
Rynek Zdrowia
Zakażenia grzybicze w hematoonkologii: warto postawić na profilaktykę

23.01.2014
dr n. med. Marta Morawska
Leczenie wspomagające na Konferencji ASH 2013

19.12.2013
dr n. med. Marta Morawska
G-CSF podany dożylnie vs podskórnie - randomizowane badanie porównujące skuteczność leczenia

7.11.2013
dr n. med. Marta Morawska




